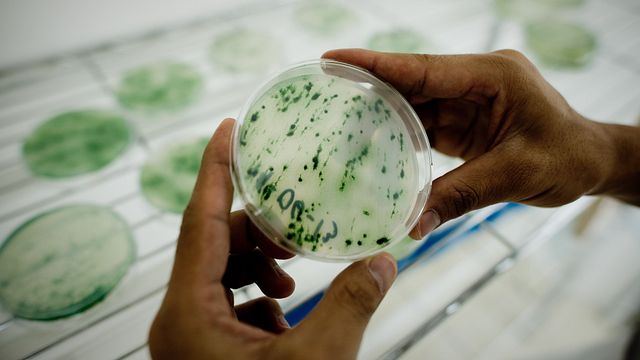

L’elettricità è il motore della modernità, è alla base di tutto ciò che ci circonda e in futuro ne avremo sempre più bisogno, anche per limitare l’uso di fonti inquinanti, la grande sfida dei nostri giorni. Per questo si stanno moltiplicando soluzioni per produrre energia con la stessa efficacia dei metodi attuali, ma strizzando l’occhio alla natura.
Un esempio arriva dall’Università di Cambridge, dove il team del Dipartimento di Biochimica, guidato dal professore italiano Paolo Bombelli, ha sviluppato un nuovo tipo di batteria decisamente verde.
Un tempo era chiamata alga blu-verde, ma il suo nome ufficiale è Synechocystis ed è un cianobatterio biologicamente simile a una pianta. I ricercatori ne hanno sfruttato le proprietà di fotosintesi per creare un piccolo sistema elettrochimico che, alimentato solo con luce ed acqua, produce corrente elettrica. Il team ha così creato una piccola batteria di 50 grammi e 6 centimetri che è riuscita ad alimentare un microprocessore. Il sistema è composto da un contenitore con acqua, cianobatteri e un anodo in alluminio che raccoglie gli elettroni generati durante la fotosintesi. Una tecnologia che potrebbe essere facilmente riprodotta su larga scala.
La speranza del team di ricerca è infatti quella di produrre energia per i sensori “internet-of-things”, termine che indica il funzionamento dei dispositivi che ricevono e trasferiscono i dati su reti wireless, ad esempio quelli usati per la domotica in casa. Questi dispositivi saranno più di un trilione nel mondo entro il 2035 e la loro alimentazione non potrà dipendere solo da miliardi di piccole batterie agli ioni di litio, materiale sempre più richiesto anche a causa del successo della mobilità elettrica. Una batteria ad alghe come quella di Cambridge potrebbe diventare una risposta al problema, perché non solo immagazzina energia come le classiche batteria, ma è in grado di generarla.
In passato si era sperimentato più volte l’uso di batteri per produrre corrente, ma si trattava sempre di organismi alimentati con zuccheri o altri composti. Lo studio di Cambridge invece ha puntato tutto sulla fotosintesi, trasformando la luce in fonte di energia. Questo accade perché gli organismi fotosintetici scompongono le molecole d’acqua grazie alla luce, generando ossigeno, elettroni e protoni. Il sistema sviluppato dalla squadra di Paolo Bonelli permette di prendere alcuni di questi elettroni e incanalarli in un elettrodo per produrre corrente elettrica.
Rispetto a una classica pila, la cui tensione elettrica è di 1,2 volt, la batteria ad alghe ne ha una di circa 700/800 millivolt. A differenza della pila, però, che dopo un certo periodo esaurisce la sua capacità, quella a cianobatterio può funzionare per più di un anno.
Un altro modo per limitare gli sprechi e i danni ambientali, grazie alla scienza e alla tecnologia.